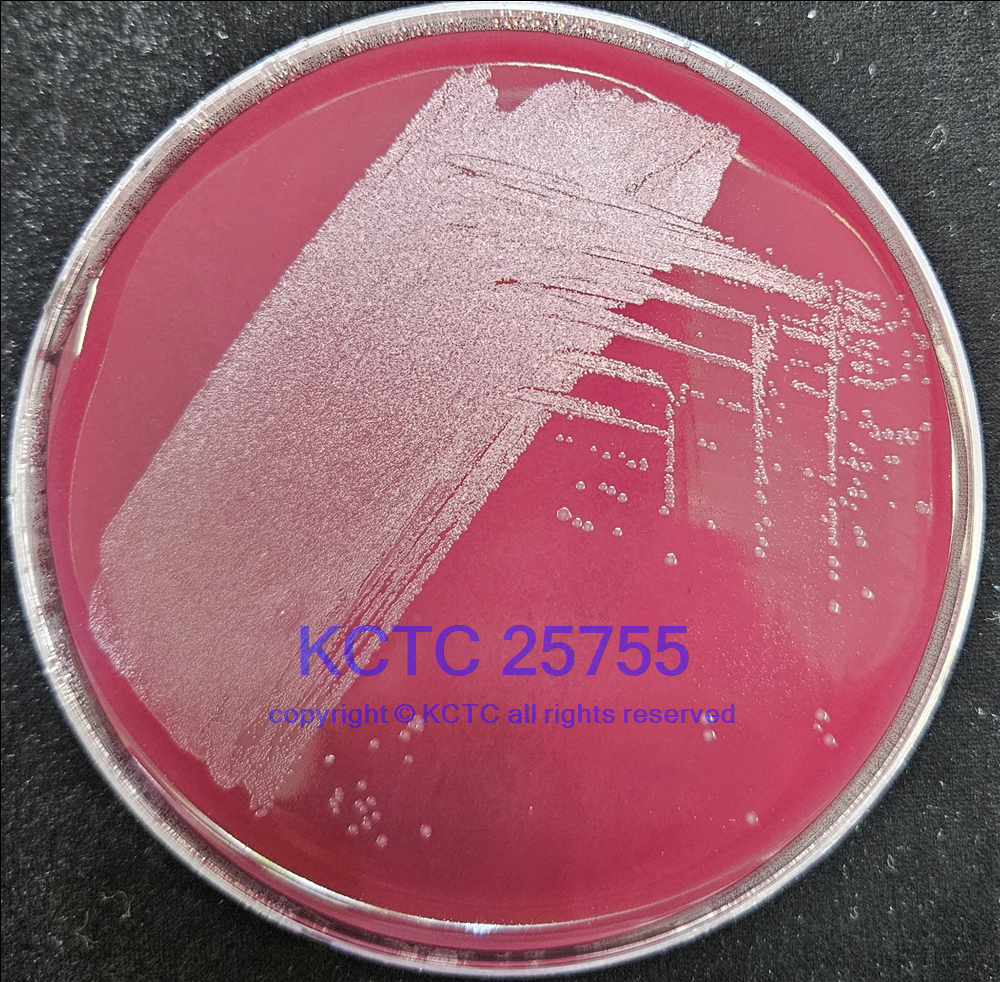

KCTC No. 25755
(KCTC Other No.)
Resource Type Bacteria
Name Olsenella urininfantis
Type Strain Yes
Biosafty Level 1
LMO No
Synonym
Phylum (ex Phylum) Actinomycetota (Actinobacteria)
Genome Information
History <- CCUG <- F Marseille, Timone, Cadoret
Source From human urine, a 26-day-old boy suffering from gastro-oesophageal reflux, Marseille, France
Other Collection No. Marseille P3197, CCUG [71847], CSUR [P3197]
Reference 10.1099/ijsem.0.004819
KCTC Media No. KCTC media No. 619 Chocolate agar
KCTC media No. 1364 TSA with 5% blood
Oxygen Requirement Anaerobic
Temperature 37 ℃
pH netural pH ?? ?? (???? ??)
Incubation Time 48h [???? ???? ????? ??, ?? ? ????? ??? ?? ?? ? ??]
KCTC 25755/KCTC25755